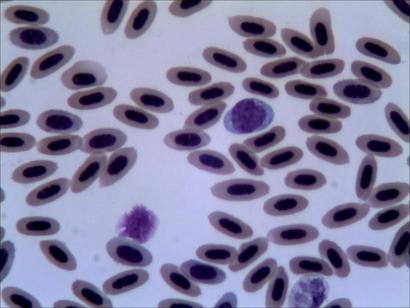
monocito.JPG

JUA dijo: a que no te he respondo a la pregunta de ante esta con el de diez por
Hola
A ver si osaclarais con el tema de los oculares y los objetivos........los oculares son los de la parte donde se miran y los objetivos son los del revolver
Jua, si las fotos que has puesto estan hechas con el objetivo de diez,hay muchas posibilidades de que lo que presentas sean megas, y nigunas de que sean levaduras, pero si estan hechas con oculares de diez y objetivo de 40 no hay posibilidades.
Pedro a tu primera pregunta te dire que si y que no, pero luego te respondo.
A tu segunda pregunta te dire que no quieras sacarle tanto partido a un micro de 100 euros, porque va a ser que no.....estas cosas de sexar animales, no se hacen con micros biologicos, se hacen con maquinaria hoy dia informatizada que son capaces de de descifrar el ADN o parte del mismo.....aunque sinceramente no se de cierto si trabajan en parte del ADN o trabajan sobre los cromosomas sexuales.
Hay algunso escritos por internet que hablan de que algunas celulas sanguineas en aves, y hablan concretamente de eritorcitos, son diferentes en tamaños entre machos y hembras.....de ser cierto esto, imagino que seria una tecnica poco fiable, y que ademas requeriria un tremendo banco de datos y una experiencia en el tema inigualable, asi que va a ser que no.
En cuato a tu segunda pregunta, si, porque es posible y no, porque es tremendamente complicado.....empezare diciendote que en ningun momento se puede pensar, algo asi como buscar coccidios en sangre...... esto a lo que tu te refieres es la atoxoplasmosis en aves......esta es una enfermedad que afecta a aves mamiferos e incluso a humanos, cada uno en su version(( humanos creo que solo somos huesped intermediarios)).......en la sangre de las aves solo se podrian ver una de las etapas del parasito, concretamente la etapa de los trofozoitos, es decir es un estado, larvario,((por llamarlo de una forma entendible)) que viaja por la sangre en busca de organos para instalarse...... estos trofozoitos circulan por la sangre, como hemos dicho anteriormente tratado de buscar alojamiento, y los leucocitos que son los encargados de limpiar la sangre de intrusos, tratan de flagocitar a los parasitos, sin saber que los intrusos tienen formas para engañarlos, y lo unico que consiguen es tramportarlos a los organos de destino, higado pancreas, bazo, cerebro, ectr, ectr, y en estos momentos de tramsporte es posible verlos montados en los leucocitos, aunque tambien pueden verse circulando por el torente sanguineo libremente, pero por supueto con tinciones especiales y un micro biologico con objetivo de imersion de aceite.
Verlos tanto de una forma como de otra, imagino que debe ser en etapas concretas de la infeccion, y digo imagino, porque yo nunca he tenido esa suerte, y el dia que la tenga, teneis una ronda pagada para todos, y sigo imaginando que no sera los mismo buscar el parasito en plena crisis de infeccion que buscarlo en un pajaro que ha sovrevivido a la infecion, y que ha quedado como portador de la misma, que logicamente seguira teniendo el parasito, pero la posibilidad de verlo se reduce al minimo…..asi que amigo Pedro,esto de buscar coccidios como coccidios en sangre va a ser que no!! aunque algo si que se puede hacer……por lo menos intentarlo, jejeje…..saludos
PD: os dejo un par de fotos.....la primera es recogida de internet, en la que se ven unos trofozoitos de atoxoplasma, formando una media luna sobre unos leucocitos......y la segunda es de cosecha propia, es sangre de jilguero, en la que ademas de los eritrocitos se contempla un leucocito, concretamente un monocito.

- Fig8.jpg (42.71 KiB) Visto 7435 veces
- monocito.JPG (20.09 KiB) Visto 7320 veces